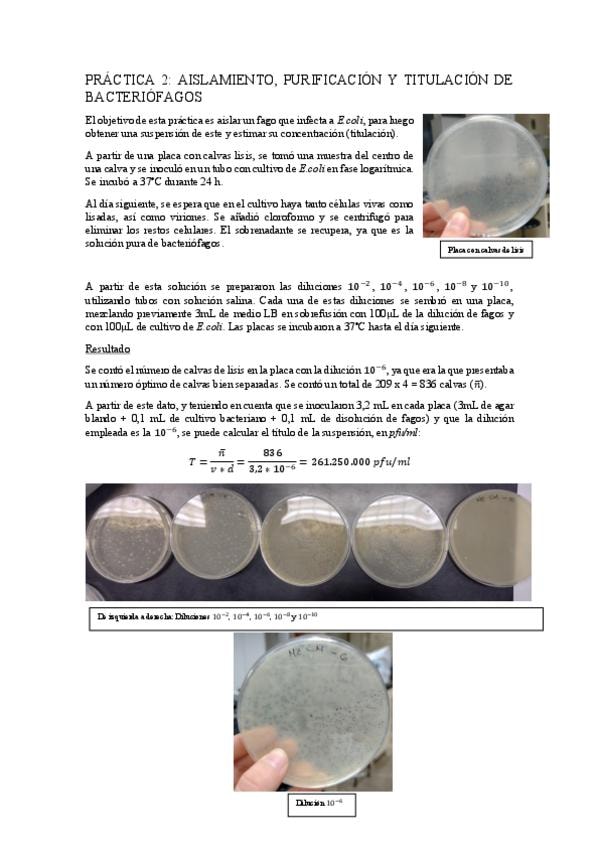

Grado en Biotecnología (UGR)
Granada
Sube tus apuntes
arrow_forwardAsignaturas de Grado en Biotecnología (UGR)
Asignatura
arrow_downward4º
•
5 posts
1º
•
83 posts
1º
•
45 posts
1º
•
97 posts
2º
•
91 posts
4º
•
3 posts
2º
•
52 posts
3º
•
28 posts
3º
•
27 posts
3º
•
15 posts
4º
•
6 posts
3º
•
18 posts
3º
•
11 posts
1º
•
70 posts
2º
•
59 posts
1º
•
155 posts
2º
•
57 posts
2º
•
41 posts
4º
•
6 posts
1º
•
89 posts
2º
•
20 posts
2º
•
7 posts
3º
•
24 posts
4º
•
0 posts
3º
•
15 posts
4º
•
4 posts
3º
•
24 posts
2º
•
31 posts
3º
•
8 posts
3º
•
4 posts
1º
•
104 posts
3º
•
19 posts
4º
•
0 posts
2º
•
22 posts
1º
•
132 posts
1º
•
87 posts
4º
•
3 posts
4º
•
1 posts
4º
•
4 posts
1º
•
83 posts
4º
•
0 posts
4º
•
9 posts
3º
•
23 posts
Últimas publicaciones de Grado en Biotecnología (UGR)
He publicado nuevos apuntes de 1º TÉCNICAS INSTRUMENTALES APLICADAS A LA BIOTECNOLOGÍA: tema5espectroscopiaatomicaUVVIS.pdf
apuntes
-
Teoría Fundamentos de Ingeniería
He publicado nuevos apuntes de 2º Fundamentos de Ingeniería Bioquímica: Teoría Fundamentos de Ingeniería
apuntes
-
Apuntes Ordinaria Micro
He publicado nuevos apuntes de 2º Microbiología: Apuntes Ordinaria Micro
He publicado nuevos ejercicios de 2º Fundamentos de Ingeniería Bioquímica: Tema-7-Transferencia-de-calor.pdf
He publicado nuevos ejercicios de 2º Fundamentos de Ingeniería Bioquímica: Tema-8-Balances-de-energia-mecanica.pdf
apuntes
-
Apuntes Ordinaria Fisio Vegetal
He publicado nuevos apuntes de 2º Fisiología Vegetal: Apuntes Ordinaria Fisio Vegetal
apuntes
-
Apuntes Fisio Animal Ordinaria
He publicado nuevos apuntes de 2º Fisiología Animal: Apuntes Fisio Animal Ordinaria
He publicado nuevos apuntes de 1º Estadística: formulario-estadistica.pdf
apuntes
-
Apuntes Genética
He publicado nuevos apuntes de 2º Genética: Apuntes Genética
apuntes
-
Apuntes y Ejercicios 2026
He publicado nuevos apuntes de 4º Productos naturales y sus aplicaciones biotecnológicas: Apuntes y Ejercicios 2026
apuntes
-
MICROBIOLOGÍA
He publicado nuevos apuntes de 2º Microbiología: MICROBIOLOGÍA
practicas
-
MICROBIOLOGÍA
He publicado nuevos practicas de 2º Microbiología: MICROBIOLOGÍA
apuntes
-
Apuntes Fisiología Vegetal Parcial
Apuntes de Fisio Vegetal hasta el parcial (U5) Actualizados con la clase de dudas
apuntes
-
Apuntes gyp
He publicado nuevos apuntes de 3º Genómica y Proteómica: Apuntes gyp
apuntes
-
Apuntes Parcial Fisio Animal
He publicado nuevos apuntes de 2º Fisiología Animal: Apuntes Parcial Fisio Animal
He publicado nuevos practicas de 1º Química Orgánica: Informe-de-practicas.pdf
apuntes
-
Apuntes
He publicado nuevos apuntes de 3º Biotecnología Microbiana: Apuntes
He publicado nuevos ejercicios de 3º OPERACIONES DE SEPARACIÓN Y PURIFICACIÓN: Ejercicio-individual-SOLUCION.pdf
He publicado nuevos practicas de 3º Virología: Informe-de-practicas.pdf
apuntes
-
Temas de virología
He publicado nuevos apuntes de 3º Virología: Temas de virología
apuntes
-
Apuntes completos de la segunda parte: PROTEÓMICA
He publicado nuevos apuntes de 3º Genómica y Proteómica: Apuntes completos de la segunda parte: PROTEÓMICA
apuntes
-
Apuntes completos de la primera parte: GENÓMICA
He publicado nuevos apuntes de 3º Genómica y Proteómica: Apuntes completos de la primera parte: GENÓMICA
apuntes
-
Apuntes Parcial Microbiología
He publicado nuevos apuntes de 2º Microbiología: Apuntes Parcial Microbiología
He publicado nuevos practicas de 1º Biología Celular: Practicas-Biologia-Celular.pdf
He publicado nuevos apuntes de 1º Biología Celular: Practicas-Biologia-Celular.pdf
apuntes
-
Apuntes Prácticas Fisio Animal
He publicado nuevos apuntes de 2º Fisiología Animal: Apuntes Prácticas Fisio Animal
He publicado nuevos apuntes de 1º Química Orgánica: Sustituciones-Nucleofilicas.pdf
He publicado nuevos apuntes de 3º Biorreactores: Esquemas-biorreactores.pdf
He publicado nuevos apuntes de 3º Biotecnología Vegetal: esquemas-2o-parcial-BV.pdf
ejercicios
-
FIB
He publicado nuevos ejercicios de 2º Fundamentos de Ingeniería Bioquímica: FIB
He publicado nuevos apuntes de 4º IMPLICACIONES SOCIALES DE LA BIOTECNOLOGÍA: Apuntes-Filosofia.pdf
He publicado nuevos ejercicios de 4º Tecnicas de bioconjugación: Ejercicio-practicas.pdf
He publicado nuevos apuntes de 1º Química Orgánica: Tema-3-Isomeria-y-Esteroisomeria.pdf
sólo os va a contar la asistencia pero aqui los teneis resueltos por si os viene bien para estudiar
apuntes
-
Apuntes Análisis Químico 25/26
He publicado nuevos apuntes de 2º ANÁLISIS QUÍMICO DE PRODUCTOS BIOTECNOLÓGICOS: Apuntes Análisis Químico 25/26
ejercicios
-
Relaciones resueltas
He publicado nuevos ejercicios de 2º ANÁLISIS QUÍMICO DE PRODUCTOS BIOTECNOLÓGICOS: Relaciones resueltas
apuntes
-
CUESTIONARIOS MOOC EMPRENDER ABIERTA UGR
TODOS LOS CUESTIONARIOS